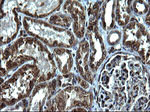
CD74 Antibody in Immunohistochemistry (Paraffin) (IHC (P))

Search
OriGene
CD74 Monoclonal Antibody (OTI1H3), TrueMAB™
{{$productOrderCtrl.translations['antibody.pdp.commerceCard.promotion.promotions']}}
{{$productOrderCtrl.translations['antibody.pdp.commerceCard.promotion.viewpromo']}}
{{$productOrderCtrl.translations['antibody.pdp.commerceCard.promotion.promocode']}}: {{promo.promoCode}} {{promo.promoTitle}} {{promo.promoDescription}}. {{$productOrderCtrl.translations['antibody.pdp.commerceCard.promotion.learnmore']}}
产品信息
CF507339
种属反应
宿主/亚型
分类
类型
克隆号
抗原
偶联物
形式
浓度
纯化类型
保存液
内含物
保存条件
运输条件
产品详细信息
For reconstitution, we recommend adding 100 µL distilled water to a final antibody concentration of about 1 mg/mL. To use this carrier-free antibody for conjugation experiments, we strongly recommend performing another round of desalting. (Zeba Spin Desalting Columns, 7KMWCO, 0.5 mL, Product # 89882)
靶标信息
HLA-DR, like other MHC class II molecules, is a transmembrane glycoprotein composed of a 36 kDa alpha chain (DRA) and 27 kDa beta chain (DRB). The alpha chain gene contains 5 exons. Exon 1 encodes the leader peptide, exons 2 and 3 encode the two extracellular domains, and exon 4 encodes the transmembrane domain and the cytoplasmic tail. DRA does not have polymorphisms in the peptide binding part and acts as the sole alpha chain for DRB1, DRB3, DRB4 and DRB5. Within the DR molecule the beta chain contains all the polymorphisms specifying the peptide binding specificities. Hundreds of DRB1 alleles have been described and typing for these polymorphisms is routinely done for bone marrow and kidney transplantation. HLA-DR is expressed primarily on antigen presenting cells such as B lymphocytes, monocytes, macrophages, thymic epithelial cells and activated T lymphocytes. Three loci, DR, DQ and DP, encode the major expressed products of the human class II region. The human MHC class II molecules bind intracellularly processed peptides, present them to T-helper cells, and have a critical role in the initiation of the immune response.
仅用于科研。不用于诊断过程。未经明确授权不得转售。
篇参考文献 (0)
生物信息学
蛋白别名: CD74; CD74 antigen; CD74 antigen (invariant polypeptide of major histocompatibility complex, class II antigen-associated); CD74 molecule, major histocompatibility complex, class II invariant chain; gamma chain of class II antigens; HLA class II histocompatibility antigen gamma chain; HLA-DR antigens-associated invariant chain; HLA-DR-gamma; Ia antigen-associated invariant chain; Ia-associated invariant chain; Ii; MHC HLA-DR gamma chain; p33
基因别名: CD74; DHLAG; HLADG; Ia-GAMMA; II
UniProt ID: (Human) P04233
Entrez Gene ID: (Human) 972